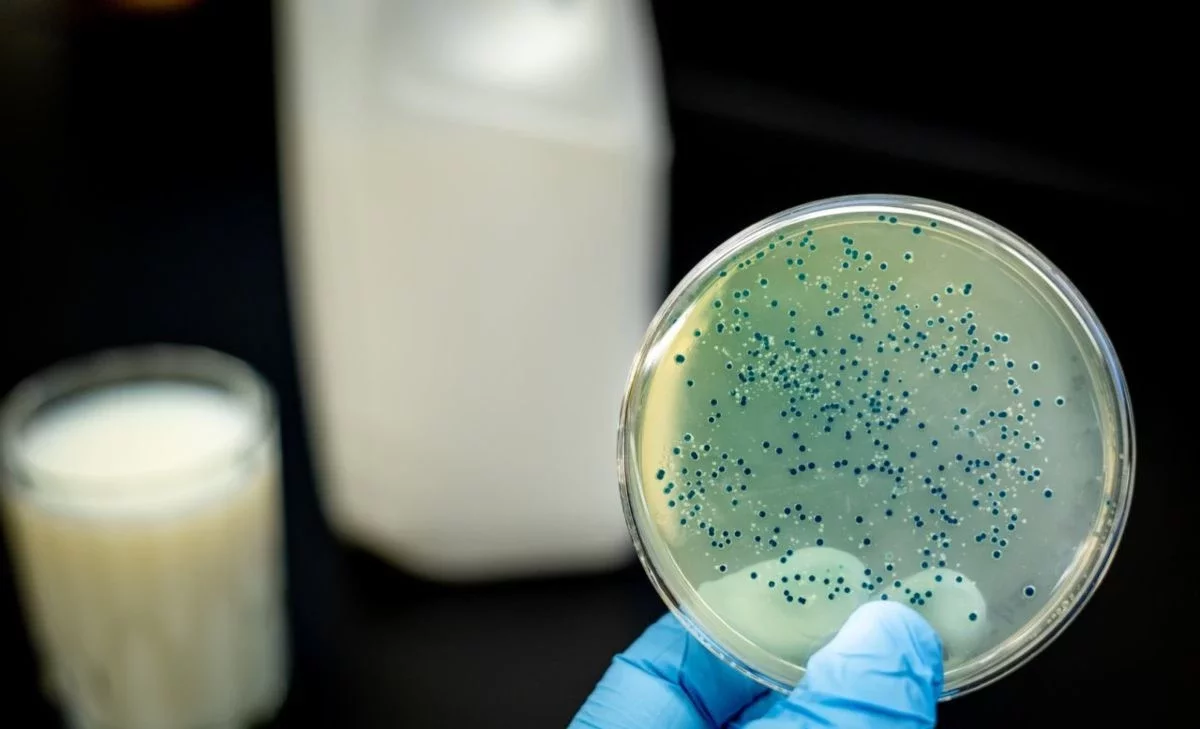

Қостанай облысында соңғы айларда бруцеллез жұқтыру жағдайы көбейіп кеткен. Соңғы 6 ай аралығында 21 адамнан осы ауру анықталып отыр, деп хабарлайды Stan.kz ақпарат агенттігі Қазақстан телеарнасына сілтеме жасап.
Дерекке сүйенсек, соңғы алты ай ішінде бруцеллез анықталған 21 адамның төртеуі бала.
Бұл былтырғы жылмен салыстырғанда 5 пайызға көп. Ал республикалық орташа көрсеткіштен 2 есе жоғары.
Бруцеллез дерті ішкі органдарды зақымдап, асқынған жағдайда кемтарлыққа соқтыруы мүмкін. Індет адамға ауру малдың етін, сүтін тұтынғанда жұғады.
“Барлық жағдайда ауырған адамдар індетті өздерінің үйіндегі жануарлардан жұқтырған. Әзірге олардың арасында дерті асқынғандар жоқ. Тиісті емшараларды қабылдап жатыр”, - дейді облыстық Санитариялық-эпидемиологиялық бақылау департаменті басшысының орынбасары Гүлім Досымова.